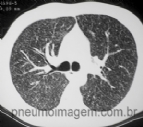

- 14 de Março de 2026 - Sábado
Notícias
PESQUISA DE IMAGENS
- ABSCESSO PULMONAR
- ANATOMIA RADIOLÓGICA
- ASMA
- BRONQUIECTASIAS
- BRONQUIOLITES
- DIVERSOS
- DOENÇA DO REFLUXO GASTRESOFÁGICO
- DOENÇAS FÚNGICAS
- DOENÇAS INTERSTICIAIS
- DOENÇAS OCUPACIONAIS
- DOENÇAS PLEURAIS
- DOENÇAS VASCULARES
- DPOC
- METÁSTASES
- MICOBACTERIOSES NÃO-TUBERCULOSAS
- NEOPLASIAS
- NÓDULOS
- OUTROS ÓRGÃOS
- PNEUMONIAS
- TUBERCULOSE
- VIAS AÉREAS SUPERIORES